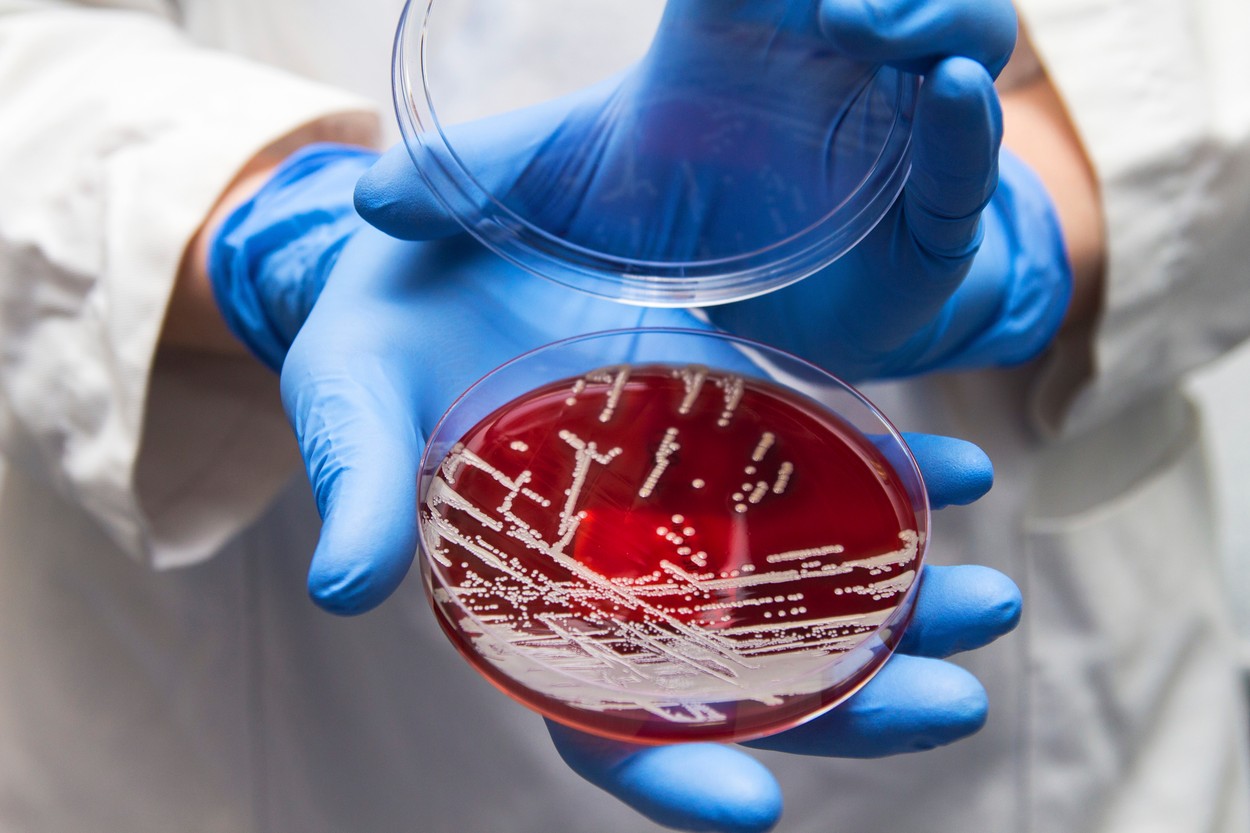
Staphylococcus aureus culture

Sjajne vijesti: Bakterije sve otpornije na antibiotike, liječnici imaju rješenje
Znanstvenici su pronašli način kako bez antibiotika liječiti kožne infekcije "zlatnog stafilokoka" koje posebno muče neke pacijente oboljele od raka, ali prijete i posjetiteljima bolnica.
Laboratorijska studija znanstvenika sa Sveučilišta u Kopenhagenu koristila je umjetnu verziju enzima koji prirodno proizvode bakteriofagi (virusi koji inficiraju bakterije) i upotrijebila ga za iskorijenjivanje Staphylococcus aureusa ili zlatnog stafilokoka u uzorcima biopsije ljudi s limfomom kože.
"Ljudima koji su teško oboljeli od kožnog limfoma, stafilokok može biti velik, ponekad nerješiv problem jer su mnogi zaraženi vrstom koja je otporna na antibiotike", objašnjava imunolog Niels Ødum sa Sveučilišta u Kopenhagenu.
"Zato pazimo da ne dajemo antibiotike svima jer ne želimo imati posla s još otpornijim bakterijama. Stoga je važno pronaći nove načine liječenja – a ne manje važno – prevencije – ovih infekcija", objašnjava Ødum.
S. aureus čest je stanovnik naše kože i nosnog trakta i općenito bezopasan. Ali to je lukavi patogen: Kada je imunitet smanjen, može izazvati razne infekcije, od manjih kožnih kao što su čirevi i apscesi pa sve do po život opasnih bolesti kao što su upala pluća i sepsa.
U bolničkom okruženju sojevi bakterija otporni na lijekove predstavljaju ozbiljan i rastući problem. S. aureus može doći u krvotok tijekom operacije ili preko medicinskih uređaja kao što su kateteri, prolazeći kroz prvu liniju obrane tijela - kožne i mukozne barijere (šmrklje).
Ljudi s oslabljenim imunološkim sustavom koji posjećuju bolnice radi redovitih tretmana kao što je kemoterapija, također su u opasnosti da pokupe neugodne superbakterije koje su postale otporne na raširene antibiotike.
Posebno su osobe s limfomom kože osjetljive na bakterijske infekcije. Nazvan kožni T-stanični limfom, CTCL je rijedak oblik non-Hodgkinovog limfoma koji počinje migriranjem T-stanica raka na kožu. Tamo te lažne imunološke stanice uzrokuju osipe i lezije prije nego što se šire na druge dijelove tijela.
Sojevi S. aureusa koji su otporni na meticilin i druge antibiotike nazivaju se MRSA i dok bolnice rade na suzbijanju infekcija MRSA-om, druge superbakterije otporne na lijekove brzo će zauzeti njihovo mjesto.
Nove metode
Dakle, u ovoj studiji, Ødum i njegovi kolege eksperimentirali su s novom klasom antibakterijskih sredstava zvanih endolizini.
Endolizini su enzimi koje prirodno proizvode bakteriofagi, virusi koji inficiraju bakterije. Nakon infekcije oni režu molekule zvane peptidoglikani koji tvore mrežaste skele u staničnoj stijenci bakterija, uništavajući bakterije iznutra.
Svaka bakterijska vrsta ima jedinstvene peptidoglikane koje pravi endolizin može selektivno ciljati. Jedan endolizin, XZ.700, testiran je u ovoj studiji na uzorcima kože ljudi sa zdravom kožom i onih s CTCL-om.
"Sjajna stvar kod ovog enzima je to što je dizajniran da prodre kroz stijenku Staphylococcus aureusa", objašnjava glavni autor i imunološki istraživač Sveučilišta u Kopenhagenu Emil Pallesen. "To mu omogućuje ciljanje i ubijanje štetnog stafilokoka i ostavlja bezopasne kožne bakterije neozlijeđenima."
U laboratorijskim eksperimentima endolizin XZ.700 ubio je sojeve S. aureusa koji su bili izolirani iz pacijenata s CTCL-om i blokirao njegove učinke na poticanje tumora na maligne T-stanice uzgojene u laboratoriju.
Tretman endolizinom također je dubinski zaustavio S. aureus u koloniziranju uzoraka zdrave kože i biopsija oštećene kože ljudi s CTCL-om. Također je uklonio kolonije S. aureusa koje su se već nastanile na koži odakle je uzet uzorak za biopsiju.
"Naši laboratorijski testovi su pokazali da endolizini ne samo da iskorijenjuju Staphylococcus aureus iz uzoraka kože", kaže Ødum, već da "također inhibiraju njihovu sposobnost promicanja rasta raka."
Iako su ovi laboratorijski eksperimenti s uzorcima biopsije kože u plastičnim posudama daleko od liječenja kožnih infekcija i raka u stvarnom okruženju, rezultati su obećavajući, prenosi Science Alert.
Znanstvenici se nadaju da bi endolizin XZ.700 mogao uništiti sojeve otporne na lijekove kao što je MRSA pa čak i biofilmove, usko povezane skupine mikroba koje je jako teško liječiti. Nedavne laboratorijske studije sugeriraju da bi to moglo biti moguće, a da S. aureus ne razvije otpornost na endolizin.
Ova zadnja točka je ključna budući da su bakterije prevrtljivi mikrobi vješti u pronalaženju novih načina za izbjegavanje liječenja antibioticima brže nego što možemo razviti nove lijekove. Potrebno je više istraživanja kako bi se doista utvrdile sve prednosti i nedostaci.
Otpornost bakterija na antibiotike rastući je problem. U Europi svake godine 33 tisuće ljudi umire od infekcija uzrokovanih rezistentnim bakterijama. Nastavi li se rast antibiotske rezistencije, svaka bi infekcija mogla postati smrtno ugrožavajuća pa bi do 2050. godine otpornost na antimikrobne lijekove mogla uzrokovati čak deset milijuna smrti u svijetu, više nego što se trenutačno umire od raka, objavljeno je u prosincu prošle godine.
Studija je objavljena u Journal of Investigative Dermatology.
N1 pratite putem aplikacija za Android | iPhone/iPad i društvenih mreža Twitter | Facebook | Instagram.
Kakvo je tvoje mišljenje o ovome?
Pridruži se raspravi ili pročitaj komentare